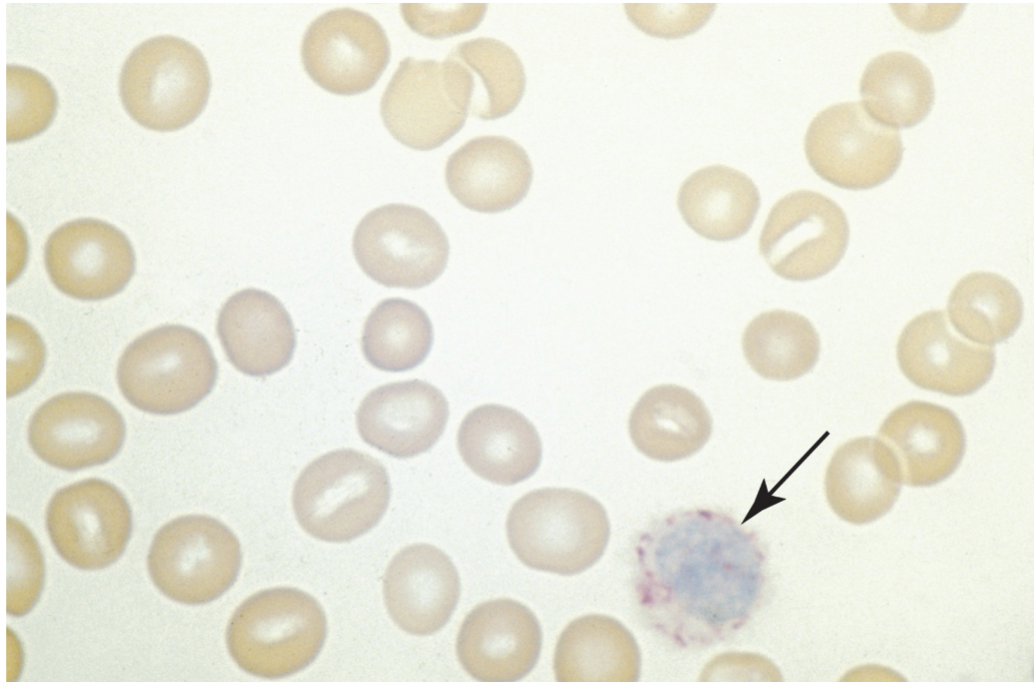

Week 13 - Acute Leukemias -- Introduction to Hematologic Neoplasms
1/122
There's no tags or description
Looks like no tags are added yet.
Name | Mastery | Learn | Test | Matching | Spaced |
|---|
No study sessions yet.
123 Terms
General characteristics of neoplasms:
Either benign or malignant
Only malignant cells are referred to as cancer
Acquired genetic diseases — most patients not born with disease but acquire it sometime later (not always the case)
Neoplasm means?:
New growth caused by dysregulated proliferation of a single transformed cell
Multiple ways to approach hematological neoplasms:

Characteristic hematologic findings in hematopoietic neoplasms:

Comparison of precursor and mature hematopoeitic neoplasms:

Neoplastic disorder categories:
Can be grouped into 3 main categories
Acute leukemia
Myeloproliferative neoplasms (MPN): bone marrow makes too many cells
Myleodysplastic syndrome (MDS): bone marrow doesn’t produce enough healthy cells
Classification
Various ways to categorize and classify
FAB and WHO are two major systems
FAB more straight forward,
Trend leaning towards WHO classification
Why is it important to classifiy neoplasms:
Can compare various therapeutic regimens
System for diagnosis using clearly defined clinical features and
laboratory evaluation
Permits meaningful associations of genetic abnormalities with
pathogenesis of disease
Two major classification systems:
Before 2001, FAB (French-American-British)
• Morphology, cytochemistry, immunophenotyping
WHO (2001, 2008, 2016, 2022) (World Health Organization)
• Morphology, cytochemistry, immunophenotyping, molecular analysis
• Based on neoplastic cell lineage
Three major groups
– Myeloid, lymphoid, and histiocytic/dendritic
Diagnosing and Classifying Neoplasms: Initial evaluation
Peripheral blood and BM samples
Aspirate and biopsy for BM
Morphology and blast count
Differentiation into cell lineage
Morphology
Immunophenotyping
Cytogenetic analysis
Molecular analysis
MDS and MPN
Immunophenotyping usually not necessary
Inital evaluation, differential diagnosis, prognosis, monitoring includes:
cytochemistry
Immunological analysis
Genetic analysis
Cytogenetic analysis
Molecular analysis
Hematologic remission:
Absence of neoplastic cells in PB and BM
Return to normal levels of hematologic parameters
Cytogenic remission:
Absence of recognized cytogenetic abnormalities associated with a given neoplastic disease
Molecular remission:
Absence of detectable molecular abnormalities using PCR or
related molecular technologies
Minimal residual disease:
Negative “traditional” tests (PB and BM cell counts,
cytogenetics)
Positive molecular tests (PCR/FISH)
Therapeutic success rates:
Differ by disease and the patient’s condition at time of
diagnosis
Often obtain remission and then relapse
Most treatment regimens
Target actively proliferating cells and not the hematopoietic stem cell
Reason for relapse – because the stem cell is responsible for propagation of neoplasm
Chemotherapy:
Goal is to eradicate all malignant cells
Allows for repopulation by residual normal precursors
Problem
Not specific for leukemic or cancerous cells
Kills many normal cells
Complications
Bleeding, infections, anemia
Three groups of chemotherapy drugs:
Antimetabolites
Alkylating agents
Anti-tumor antibiotics
Molecular treatment:
Target genetic mutations
Epigenetic therapies:
Drugs attempting to alter gene expression
Bone marrow transplant/stem cell transplant:
Try to replace with healthy stem cell
Hematopoietic growth factors:
Supportive care of acute leukemic (AL) patients
Erythropoeiten, G-CSF, GM-CSF, Interleukin-11
Complications of Treatment:
Aggravate patient’s clinical situation
↑ uric acid from cell turnover
Precipitates in renal tubules
Leads to renal failure
Lysed cells
Release procoagulants
Disseminated intravascular coagulation (D I)C) and hemorrhage
Chemo destroys normal and leukemic cells
Causes infection, bleeding, anemia
Acute Leukemias:
AML,ALL
Chronic Leukemia (CL):
CLL, PLL, HCL, CLTC, Mature B, Mature T
Myeloproliferative Neoplasms (MPN)
CML, Myelofibrosis, Polycythemia, ET, other MPN’s
Myelodysplastic Syndrome (MDS):
Group of syndromes
Lymphoma’s and Plasma Cell Disorders:
Hodgkin’s, Burkitt's, Mantel Cell, Marginal B-Cell, Sezary Syndrome,
Multiple Myeloma, Waldenstroms, PCL
Acute Leukemia (AL): ALL and AML general characteristics:
stem cell disorders characterized by malignant neoplastic proliferation and accumulation of immature and nonfunctional hematopoietic cells in the bone marrow
Two major categories of AL are classified according to the origin of the cell with the primary defect:
acute myeloid leukemia (AML): defect primarily affects common myeloid progenitor
acute lymphoblastic leukemia (ALL): defect primarily affects common lymphoid progenitor
Definition of Leukemia:
Mutation of stem cells in the bone marrow, causing impaired production of normal RBC’s, WBC’s and Platelets
Characterized by unregulated proliferation of cells with replacement of normal bone marrow cells
A gap in normal maturation form of cells
Alterations in BM = production issues, spleen becomes site of extramedullary hematopoiesis
Leukemias are categorized based on cell lineage and maturity:
Acute myeloid leukemias (AML)
Acute lymphoblastic leukemias (ALL)
Chronic myelocytic leukemias (CML)
Chronic lymphocytic leukemias (CLL)
2 Major cell types with both acute and chronic forms:
Myelogenous or Lymphocyte
Acute or chronic
Cell maturity: Acute:
Immature cell types predominate
Cell maturity: Chronic
More mature cell types predominate
Usually seen in adults
Characteristics of Acute Leukemia
Rapid onset
Short duration
Disease seen at any age
Variable WBC count
PLT count usually decreased
Anemia: mild
Normocytic/Normochromic with decreased amount of RBC
Fatal within months if not diagnosed and treated aggressively
Blasts and immature cells are observed in the bone marrow and peripheral smear
FAB Classification
>30% blasts in bone marrow
WHO Classification
>20% blasts in bone marrow
Leukemia sub classification:
Morphology, cytochemical stain, immunologic criteria, molecular analysis
FAB Classification of Leukemia:
AML – Acute Myeloid Leukemia
M0 – M7
CML – Chronic Myeloid Leukemia
ALL – Acute Lymphoblastic Leukemia
L1 – L3
CLL – Chronic Lymphocytic Leukemia
ANLL – Acute Non lymphocytic Leukemia
Acute Leukemia: General Features:
N/N Anemia
Fatigue, malaise, pale appearance
Thrombocytopenia
Gingival bleeding, epistaxis, ecchymosis, petechiae
Fever
WBC variable
Hepatosplenomegaly, lymphadenopathy, or bone pain
and tenderness
Acute Leukemia defect:
Blasts do not mature
Leukemic cells are arrested at an immature stage
Leukemia Hiatus: presence of blast cells and mature cells without an orderly morphologic progression between the 2
Lack of normal differentiation antigens and are unable to respond to normal regulatory feedback control


Neoplasia in Common Myeloid Progenitors AML
French-American-Britich (FAB) Classification of AML:
2016 WHO Classification of Myeloid Malignancies:
Histopathological features
Genetic features
Pathogenesis of neoplasms
Standardization of nomenclature
Advances in therapy

The large mononuclear cells are myeloblasts. The cell at the left (arrow) is a myeloblast with an Auer rod. Note the high nuclear-to-cytoplasmic ratio, the fine lacy chromatin, and the prominent nucleoli. (Wright-Giemsa stain, 1000× magnification)
Genetic Susceptibility:
Congenital abnormalities associated with karyotype abnormalities (Down’s Syndrome)
Somatic Maturation:
Acquired change in genetic material of cells (radiation, chemicals i.e. benzene)
Viral Infection:
Retroviruses are proven to be responsible for leukemia in lab animals (Human T Cell Leukemia/Lymphoma)
Immunological Dysfunction:
Increased incidence of lymphocytic leukemia has been observed in both congenital and acquired immunological disorders. Breakdown in cell mediated immune self surveillance
Classification of any type of leukemia:
Morphology alone is ineffective
Call blasts “blasts” on peripheral smear, don’t differentiate
Definition of Blast: earliest, least differentiated stage of hematopoietic maturation that can be identified by its morphology in a wright stain (typically in) bone marrow - for example: Myeloblast, Pronormoblast (Rubriblast), Lymphoblast
Other methods: cytochemical stains, CD markers, chromosomal analysis, molecular testing
Cytochemical Analysis:
Used to identify the chemical composition of cells without
altering the cell morphology
Often performed on bone marrow slides
Enzymatic reactions:
Peroxidase, Esterases, Phosphatases, Terminal deoxynucleotidyl transferase (TdT)
Non-enzymatic reactions:
Sudan Black, Periodic Acid Shift (PAS), Toluidine Blue
Staining profiles: Myeloid:
Peroxidase and Sudan Black POSITIVE
Staining profiles: Lymphocytic:
PAS and TdT POSITIVE
Staining profiles: Basophil:
Toluidine POSITIVE
Peroxidase:
Myeloperoxidase (MPO) stain used as a marker for primary neutrophilic granules
Not found in lymphs
NEED: freshly prepared blood or bone marrow
Peroxidase activity disappears
Enzyme dissipates after awhile = need fresh sample
ONLY evaluate the BLAST cell
Myeloid +
Lymphoid -

Peroxidase present in primary granules of myeloid cells.
Enzyme not present in lymphocytes (or precursors)
Useful to differentiate between AML and ALL
More specific then Sudan Black B
Image shows + peroxidase in M3 (APL)
Esterase:
Differentiate granulocytic from monocytic
2 Types: specific and non-specific
Specific Esterase:
Naphthol AS-D Chloroacetate (CAE)– granulocytic marker (primary granules)
Non-Specific Esterase:
Alpha-Naphthyl-Acetate (ANAE)
Alpha-Naphthyl-Butyrate
These are useful markers for monocytes
Combined Esterase:
Combination of both

Specific
Naphthol AS-D Chloroacetate
Granulocytic
+AML - M2

Non-specific
Alpha-naphthyl butyrate
Monocyte
+AML - M5
Phosphotase:
Acid phosphatase: present in all hematopoietic cells.
When tartaric is added all cells become negative EXCEPT hairy cell lymphoma.
Known as TRAP stain (Tartrate Resistant Acid Phosphatase)
Leukocyte Alkaline Phosphatase (LAP):
enzyme activity found in the secondary granules of neutrophils.
Used to differentiate CML from Leukemoid reaction
Decreased with CML
Increased with Leukemoid reaction
LAP Score (used to grade granulation of neutrophil):
Normal 13-130 (may vary slightly from lab to lab)
Greater then 160 usually considered increase
Lower then 13 usually considered decreased
Range of assay (0-400)
100 segmented neutrophil/bands are counted.
Each cell is graded using scale 0 - 4+ according to appearance (amount and intensity of precipitated dye)

Example of LAP Calculation:
Terminal Deoxynucleotidyl Transferase (TdT):
Enzyme marker for primitive lymphocytes
A DNA polymerase found in immature lymphocytic cells
High levels have been found in 90% of all cases of ALL
Can use in conjunction with various immunological techniques (immunofluorescence, flow cytometry, immunohistochemistry)
Periodic Acid Schiff (PAS):
Non enzyme reaction that stains glycogen, mucoproteins, glycoproteins, glycolipids, and polysaccharides.
Stains lymphocytes, granulocytes, monocytes, and megakaryocytes.
Glycogen found in all leukocytes, but patterns differ
Granulocytes and myeloblasts: diffuse pattern
Monos: weak stain
Lymphs of ALL (80%) chunky or block like
Not frequently used for classification or identification of Acute leukemia’s

PAS positive in Acute Lymphoblastic Leukemia (ALL)
Note the “block staining” pattern
Sudan Black B (SBB):
Non-enzyme reaction which stains intracellular lipids
Also stains neutral fats and phospholipids
SBB most sensitive for granulocytic precursors
More stable
Because it doesn't depend on enzymes
Particularly useful for specimens that aren’t fresh
Closely parallels myeloperoxidase (MPO)

Toluidine Blue:
Basic dye that reacts with mucopolysaccharides
Specific for the basophil and mast cell

Special Stains Chart
CD Markers: Cluster of Differentiation:
A system of nomenclature developed in order to label membrane proteins or complexes of proteins in which physical properties or interactions with monoclonal antibodies are known
Designations are most commonly seen on hematopoietic cells
Can test for cell surface markers using monoclonal antibodies (against specific marker)
Use immunohistochemistry or flow cytometry analysis
Flow Cytometry:
Yields information regarding biophysical and biochemical nature of a cell
Device design
Analysis is by light scatter and fluorescence dyes that have been tagged with monoclonal antibodies
Look at side scatter and forward scatter to investigate cell population
Gating: defined boundary that can be used to identify a refined cellular population

Flow Cytometry to study cell populations
Gating created to distinguish cell populations of interest

Flow cytometry and fluorescence to analyze cell surface markers
Quadrants in scatter plot designate presence or absence of markers

Common CD markers

Characteristic Immunophenotype of Lymphoproliferative Disorders

Flow Cytometric Requirements for Assigning Blast Lineage

Commonly analyzed Markers

AML Phenotype
Acute Myelocytic Leukemia:
Occurs primarily in the adult or infants (less then one year)
Myeloid stem cell that mutates and losses ability to proliferate and differentiate
Relatively immobile cells confined to the bone marrow
n/n anemia, PLT count decreased, WBC vary high – low
Increase in pseudo pelger-huet, Eos and Baso
Helpful when Auer Rods are found
never in lymphs
AML subtypes:
M0, M1, M2, M3, M4, M4EO, M5a, M5b, M6, M7
AML - M0:
Minimally Differentiated
Blast are cytochemically unreactive
Myeloid and Monocytic antigens can be detected
CD11, CD14, CD34, CD117
Frequency around 5%
Poor Prognosis
AML - M0 Immunophenotype:
CD13+, CD33+, CD117+, HLA-DR±, CD34±, CD38+
M1: Myeloid Leukemia without Maturation:
Seen in young to middle age adults
Predominant cell myeloblast, +/- auer rods
Frequency 10%
MPO+, SBB+, CAE+
CD13, CD33 myeloid markers
High WBC count
Poor Prognosis

M1 Immunphenotype:
CD13+, CD33+, CD34±, CD117+, HLA-DR±
Without maturation:
Myeloblasts are large with scant amount of gray blue cytoplasm
Nucleus can be round to oval with fine chromatin
Usually very distinct nucleoli
Auer rods present in about 50% of cases

M2 - With Maturation:
More mature then the blast seen
50% blasts and 50% are beyond the blast
Auer rods usually not present
Blasts tend to look monocytic
Frequency of occurrence ~ 30-45%
Most common in adults
MPO+, SBB+, CD13 and CD33
Diagnostic translocation chromosome 8;21
(q22;q22)
Favorable prognosis
M2 Immunophenotype:
CD13+, CD33+, CD65+, CD11b+, CD15+, HLA-DR±
M3 - Promyelocytic:
Acute Promyelocytic Leukemia (APL)
More common in young adults (males)
Often massive bleeding due to thrombocytopenia and DIC
Bi-lobed promyelocytes containing primary granules (heavy) Auer rods in bundles cigar shaped (faggot) cells
Chromosome abnormality t(15;17) (q22;q12)
Frequency of occurrence ~ 10%
MPO+, SBB+, SE+, PAS-
M3 Immunophenotype:
CD13±, CD33+, CD34−, HLA- DR-
M3v - Acute Promyelocytic Leukemia: microgranular variant:
Very tiny or non-visible granulation
Bi-lobed nucleus resembling a monocyte
Often confused with monocytic leukemia
Higher WBC count than M3
Frequency ~ 20 – 30% of cases
Abnormal karyotype t(15;17)
MPO+, SBB+
Prognosis good with the t(15;17)
M3v Immunophenotype:
CD13±, CD33+, CD34−, HLA- DR−, CD64+, CD117±
M4 Myelomonocytic:
Predominant cells: myeloblast and monoblast
More common in males >50% or occurring in the first few months of life
Soft tissue infiltrates (gums)
Highest of WBC
Frequency of occurrence ~ 20%
Lysozome and muramidase +
MPO+, SBB+, NSE+, SE+
CD 13, 33 – Myeloid
CD14, 4, 11c, 64 - Monocytic
M3 Myelomonocytic Immunophenotype:
CD13+, CD33+, CD14+, CD4+, CD11b+, CD64+, CD15+, CD36+
M4EO - Eosinophilia:
Acute myelomonocytic leukemia with eosinophilia
Also referred to as AML with inv(16) (13.1;q22)
Variant type characterized by increase of eosinophils
Bone marrow Eos dysplastic with many large granules
Frequency 4%
Chromosomal abnormality: inversion of chromosome16
Has Central Nervous System involvement
M4EO - Immunophenotype:
CD34+, CD117+, CD13+, CD33+, CD15+, CD4+, CD11b+, CD11c+, CD14+, CD64+, CD36+, CD65+
M5 - Monocytic:
Very high WBC counts
Predominance of monoblasts
More prevalent in males and younger patients
Adult males >49 years of age
Gum and skin involvement
CNS and renal involvement
Frequency of occurrence 5-15%
MPO-, SBB-, NSE+
Chromosome abnormality: translocation 9q to 23
CD14, 4, 11c, 36, 64, 88
Unfavorable prognosis
2 subtypes 5a and 5b
M5 Immunophenotype:
CD33+, CD13+, CD4+, CD14+, CD11b+, CD64+,
CD15+, CD65+, CD11c+, CD36+, CD68+, HLA-DR+
M5 Subgroups: M5a - Poorly Differentiated:
1-3 nucleoli
Cytoplasm more abundant, tends to be large and irregular in shape
Monoblasts account for about 80% of all monocytic cells
Remaining 20% are monocytes
Patients typically younger and have poor prognosis
M5 Subgroups: M5b - Well Differentiated:
All stages of monocytes seen
More than 80% of monocytic cells located in nonerythroid
marrow
Remaining cells are promonocytic and monocytic
Less then 30% blasts
Gum infiltrates, skin rashes
MPO-, SBB-, NSE+

